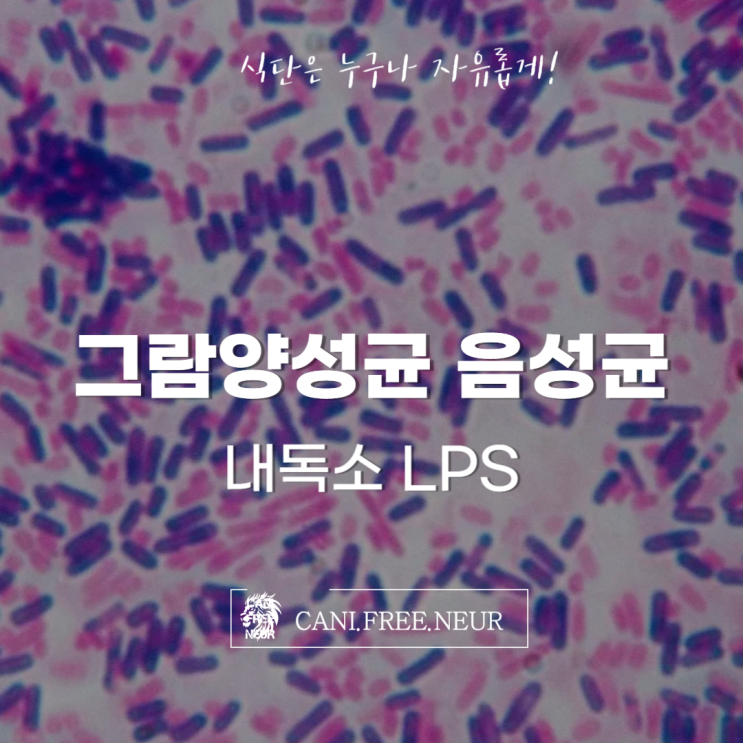

고혈압의 원인 혈관 확장 수축 : 인슐린 저항성
2025.08.30

거의 모든 고혈압 환자는 인슐린 저항성을 가지고 있습니다. 즉, 고혈압 진단을 받았다는 것은 이미 인슐린...
출처
https://blog.naver.com/1min_insight/223986573732
이슈모어 핫이슈
-
 모모랜드 낸시, 무대 밖에서도 시선 집중…글로벌 행보와 ‘화이트 스프링’의 현재
모모랜드 낸시가 다시 한 번 주목받고 있다. 그룹 활동, 글로벌 프로젝트, 그리고 음악과 연기를 오가는 행보…
모모랜드 낸시, 무대 밖에서도 시선 집중…글로벌 행보와 ‘화이트 스프링’의 현재
모모랜드 낸시가 다시 한 번 주목받고 있다. 그룹 활동, 글로벌 프로젝트, 그리고 음악과 연기를 오가는 행보…
-
 현아, 논란 대신 음악을 택했다… ‘못(Mrs. Nail)’로 드러난 현재형 선택
돌아온 현아, 논란 대신 음악으로 증명한 현재형 존재감 현아가 다시 음악으로 자신의 현재를 증명하고 있다. …
현아, 논란 대신 음악을 택했다… ‘못(Mrs. Nail)’로 드러난 현재형 선택
돌아온 현아, 논란 대신 음악으로 증명한 현재형 존재감 현아가 다시 음악으로 자신의 현재를 증명하고 있다. …
-
 고아라, ‘춘화연애담’으로 금기 넘나든 선택…일상이 화보처럼 보이는 이유
고아라가 티빙 오리지널 드라마 ‘춘화연애담’을 통해 오랜만에 주연으로 돌아온다. 데뷔 이후 청순하고 단정한 …
고아라, ‘춘화연애담’으로 금기 넘나든 선택…일상이 화보처럼 보이는 이유
고아라가 티빙 오리지널 드라마 ‘춘화연애담’을 통해 오랜만에 주연으로 돌아온다. 데뷔 이후 청순하고 단정한 …
관련 포스팅
Copyright blog.dowoo.me All right reserved.